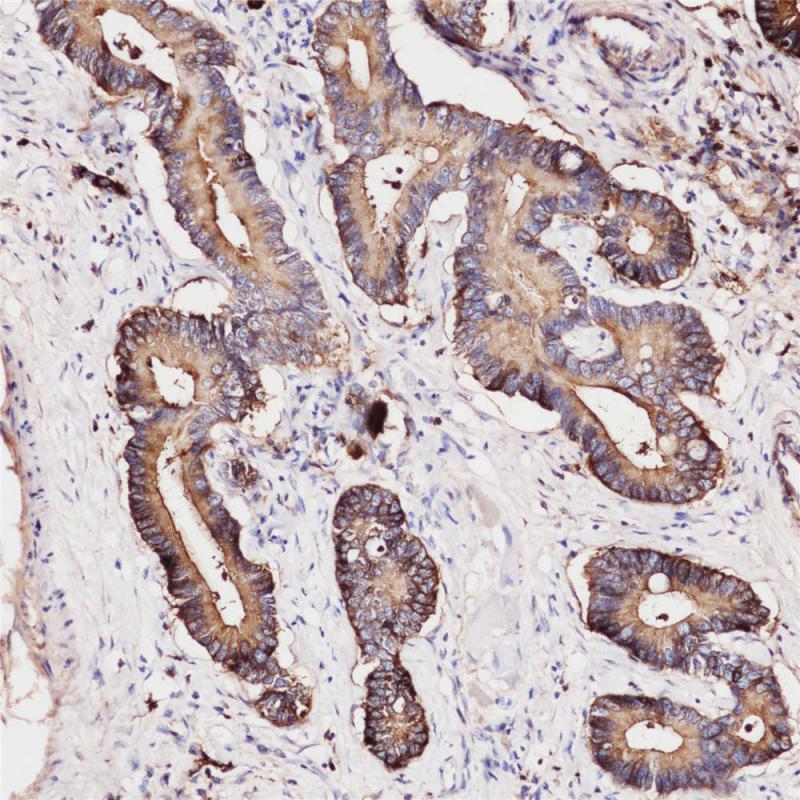
结肠癌 CEA (BP6085) 染色

产品中心

胃癌 CEA (BP6085) 染色
结肠癌 CEA (BP6085) 染色
CEA 重组兔单克隆抗体
癌胚抗原(CEA)是结直肠癌组织中产生的糖蛋白。 正常成人组织中,CEA在顶端边界表达,而在细胞质中有弱表达,如结肠的柱状细胞,小肠,胃(表面上皮,颈粘液细胞和弱表达于幽门粘液细胞),胰腺导管 ,汗腺的分泌上皮,舌的鳞状上皮细胞,食管,子宫颈和尿路上皮。 CEA抗体有助于腺癌分类,特别是在胃肠道中,包括结肠癌和胰腺癌。 IHC结果还有助于区分分泌型脑膜瘤和甲状腺髓样癌。
Specifications
- 目录号
- BX50080
- 克隆号
- BP6085
- 阳性对照
- 结肠癌
- 亚细胞定位
- 细胞质/腔膜
- 组织类型
- FFPE
- 修复方式
- HIER
- 稀释比
- 1:100-1:200
- 规格
- 100μl/vial, 1ml/vial
- 用途
- RUO
Reference
1.Probst-Cousin S, Villagran-Lillo R, Lahl R, Bergmann M, Schmid KW, Gullotta F. Cancer 1997,79:2003-15.
2.Nollau P, et al. Cancer Res. 1997 Jun; 57(12):2354-57.


